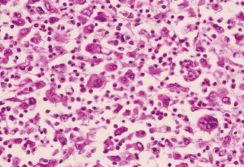
肺癌诊疗进入精准医学新时代

|
——“肺癌规范化诊疗万里行”项目在广州启动 近日由国家卫计委肺癌质控中心、卫计委临床病理质控中心、中国临床肿瘤学会及中国胸部肿瘤研究协作组四家机构联合发起的“精准医学规范前行——肺癌规范化诊疗万里行”项目在广州正式启动。 普及EGFR突变检测,提高肺癌靶向治疗精准度 肺癌是发病率和死亡率增长最快,对生命威胁最大的恶性肿瘤之一。根据世界卫生组织的数据,每年全球有超过180万个新发肺癌案例,其中有653,000例发生在中国。大约85%的肺癌患者是非小细胞肺癌,这些患者通常为肺癌晚期,存活率很低。
目前,靶向治疗已经成为非小细胞肺癌临床治疗的重要手段。多项临床研究表明,EGFR基因突变与非小细胞肺癌靶向治疗的疗效具有相关性,绝大多数EGFR基因突变阳性的病人使用靶向治疗疗效显著。但截至2014年,全国内地EGFR基因突变检测率仍只有约27%,对比日本、韩国以及中国香港、台湾地区超过80%的检测率相去甚远。要实现肺癌的精准医学,就必须进一步提高EGFR检测率,从而实现个体化治疗,并让患者获得最大生存获益。目前临床上的每一例新发的晚期非小细胞肺癌患者,第一步都应该明确EGFR基因突变状态,然后再考虑进行后续的针对性治疗,千万不要盲目地化疗或靶向治疗。 肺癌必须规范化、个体化治疗 目前肺癌的治疗主要有手术、化疗、靶向治疗、放射治疗、介入治疗、免疫治疗等,面对种类繁多的治疗手段。由于各个专业的医生对肺癌疾病的认知不同,使得肺癌在临床诊断和治疗方面存在着一定的偏差,同样的病人、同样的临床资料在不同的医院和医生手里可能会得到截然不同的治疗方案,这在一定程度上造成肺癌治疗的不规范。如何根据患者的实际情况,制订合理的个体化治疗方案,是摆在每个肿瘤医生面前必须解决的紧迫问题。
吴一龙教授介绍:“肺癌规范化诊疗万里行”项目的成立旨在“精准医学,规范前行”,在精准医学时代,我们需要提高肺癌规范化诊疗水平,中国的肺癌专家们将在“万里行”项目中共同制定订肺癌基因血液检测共识,规范多学科治疗模式,共同推动我国肺癌诊疗方向的人才培养和专科建设,保障医疗质量和医疗安全,改善医疗服务,不仅延长肺癌患者生存时间,更要提高患者生活质量。 接下来的6~8月,“肺癌规范化诊疗万里行”项目将在全国28个城市陆续召开肺癌规范化巡讲,覆盖超过3000名临床医生,对肺癌相关临床科室进行规范解读和教育,同时将成立核心专家组,着力于诊疗规范的建立、专业培训认证及对医生的继续教育,以推进肺癌诊疗规范化及精准医学的进一步发展,从而更好地造福中国肺癌患者。 肺癌诊疗进入精准医学新时代
什么是精准医学?按照美国癌症研究所的定义,是利用疾病的遗传信息的异常来针对疾病的诊断和治疗。中国临床肿瘤学会(CSCO)主任委员,广东省人民医院副院长吴一龙教授作为此次项目的发起人表示:“近些年,肿瘤分子诊断的发展及靶向药物的广泛应用,推动了癌症治疗进入精准医学新时代。以非小细胞肺癌为例,我们对于疾病的认识已经从传统意义上的病理分型进入到了基因指导下的分子分型。按照各类基因检测结果,我们可以让患者得到更有针对性的治疗,这不单能让患者活得更长、活得更好,同时也能够对各类医疗资源进行更为合理的配置,提高肺癌整体诊疗水平。” 《抗癌之窗》本刊记者 张晓丹 (责任编辑:康复乐园) |
“肺癌规范化诊疗万里行”,肺癌诊疗进入精准医学新时代
时间:2015-10-19 13:59来源:未知 作者:康复乐园 点击:
次
“肺癌规范化诊疗万里行”项目在广州启动,近日由国家卫计委肺癌质控中心、卫计委临床病理质控中心、中国临床肿瘤学会及中国胸部肿瘤研究协作组四家机构联合发起的“精准医学规范前行——肺癌规范化诊疗万里行”项目在广州正式启动。
顶一下
(0)
0%
踩一下
(0)
0%
------分隔线----------------------------
- 上一篇:肺部有结节不等于肺癌前兆
- 下一篇:腹膜后肿瘤需要个性化综合治疗